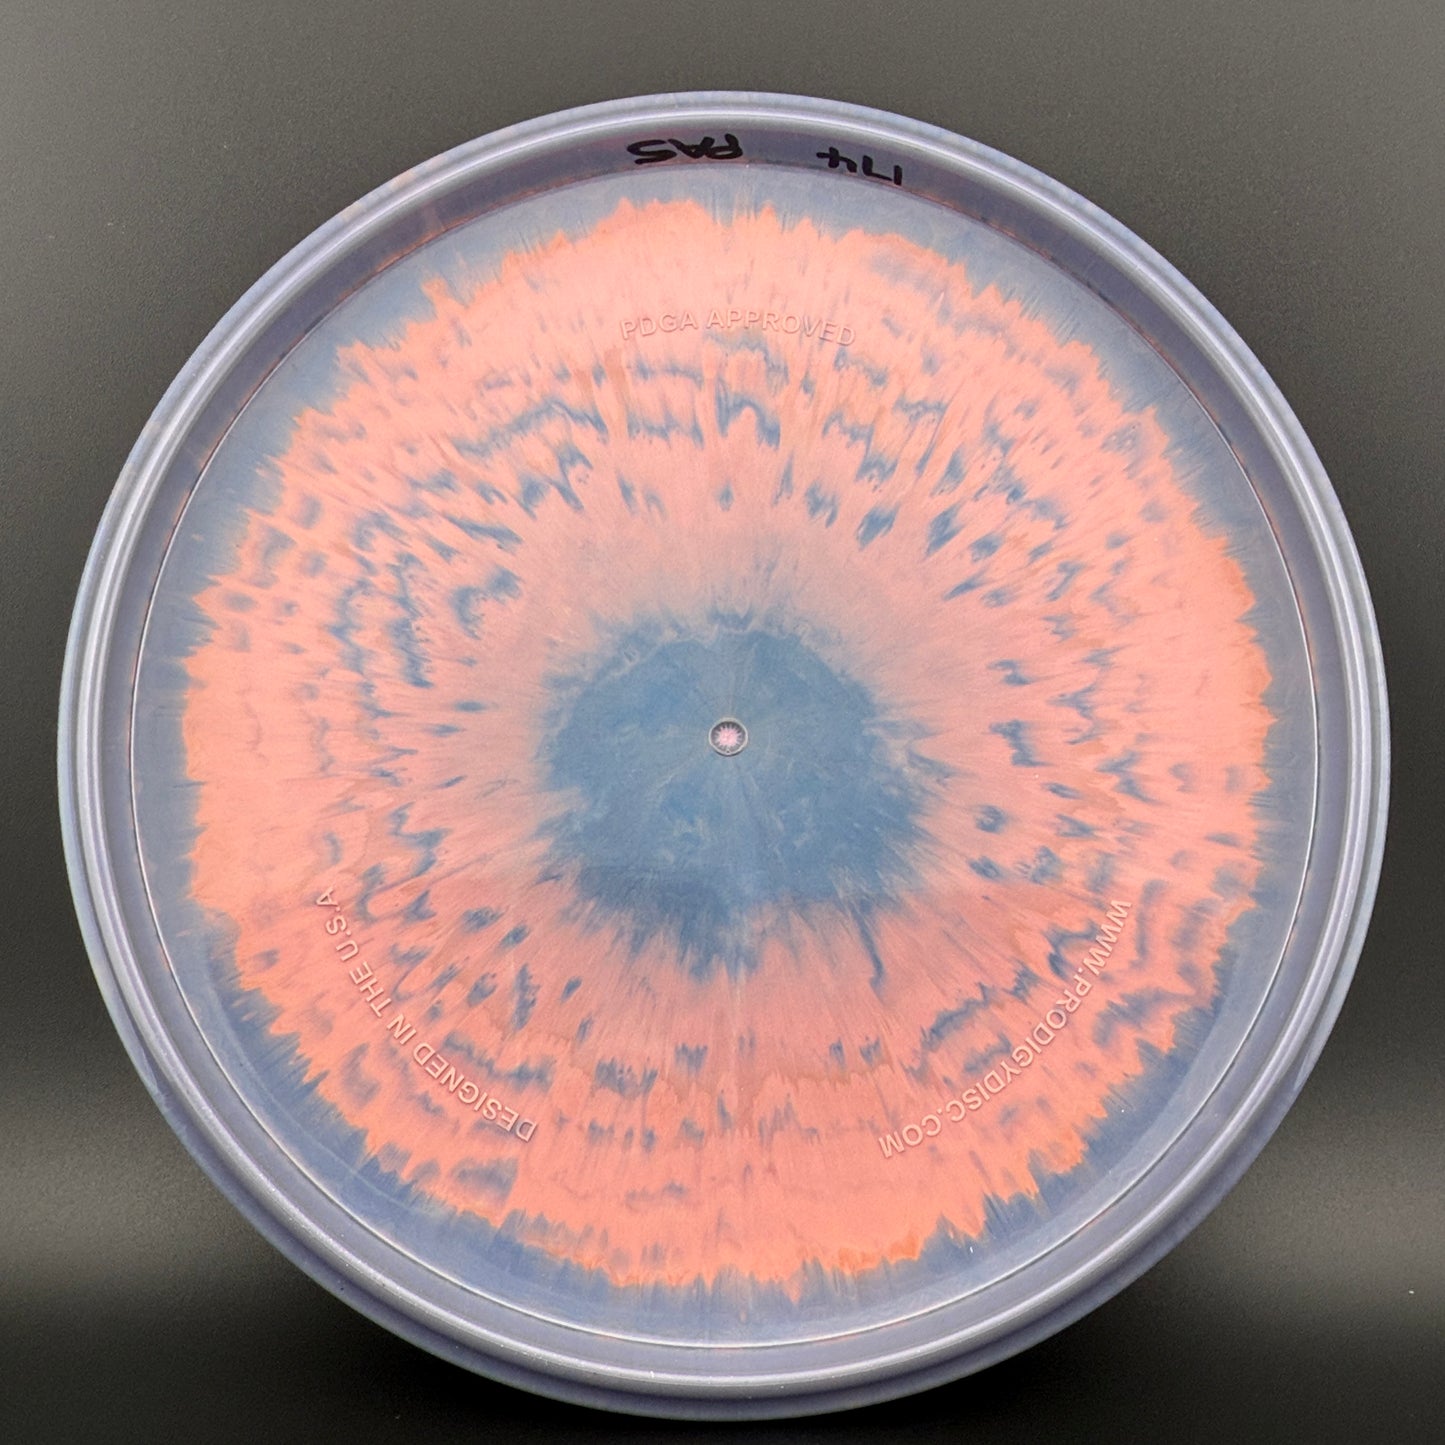
PA-5 (400 Spectrum) - Bomber Ring

Prodigy
PA-5 (400 Spectrum) - Bomber Ring
PA-5 (400 Spectrum) - Bomber Ring
Couldn't load pickup availability
Product Description
Product Description
3/4/-2/0.5 *Limited run of PA-5's in some nasty swirly 400 Spectrum plastic! These PA-5's are a customer favorite and have firm feel to them.
The PA-5 is a silky smooth understable putter that will hit beautiful slow turnover lines and dead straight hyzerflips. It has a narrow feel in the hand for an easy release. That shape also gives it a little more speed that you will quickly notice as you throw it. For putting, the PA-5 fits players who like a straight putter with little movement right or left out of the hand, and it works nicely from long distance.
400 Spectrum plastic is a premium blend known for its exceptional durability and grip, even in wet conditions. It features a stiff rim and a "pop" when flexed, providing a consistent feel. The Spectrum line showcases intricate, multicolor patterns, making each disc visually unique. This combination of performance and aesthetics makes 400 Spectrum plastic a popular choice among players seeking both reliability and standout appearance in their discs.
Share